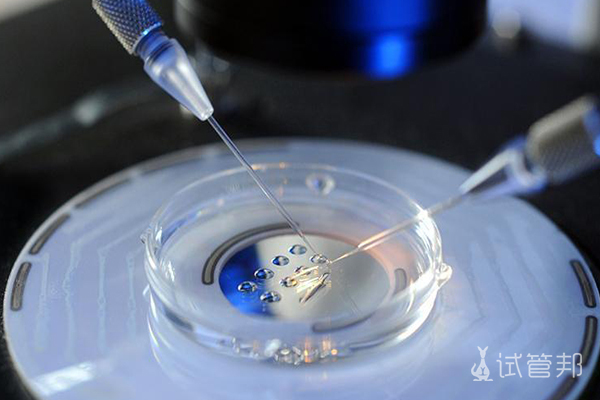
fb7c2ef3d864a92cf7ecfa573393df1d.jpg 什么是植入前基因筛查(PGS)
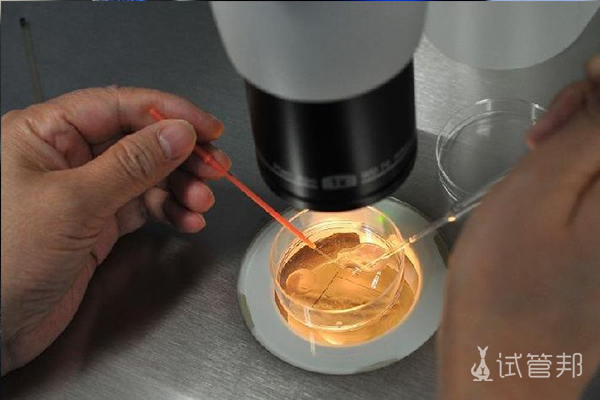
c78025c838519f29d0dc3e733b1fe3da.jpg 试管婴儿囊胚经过PGS筛选成功率是多少

生育是人类延续后代的重要方式。DNA把父母的一些身体特征代代相传,但是对于有遗传病史的家庭来说,想要一个健康的孩子是一个大问题。而试管婴儿技术PGD植入前基因筛查和植入前染色体筛查PGS的出现,为这些家庭实现了生育的梦想。那么,试管婴儿囊胚PGS通过率有多高?什么是植入前基因筛查(PGS)呢?
PGS(也被称为非整倍体筛查)包括检查IVF或ICSI所产生的胚胎的染色体。染色体异常是胚胎植入失败和流产的主要原因。它们也可能引起唐氏综合症等疾病。
PGS使科学家能够准确观察胚胎内部并检查其遗传组成,以便帅选出有最大机会长成健康婴儿的胚胎被选择移植到妇女的子宫中。
近年来,科学家们已经取得了许多进步,提高了准确性和安全性的PGS。几年前遗传学家只能评估10条染色体,达到80%的诊断准确率。今天的PGS筛查可以同时评估所有23对染色体,准确率更高。
在PGS,遗传学家评估一些活检的细胞从每个胚胎染色体非整倍体,试图找出如果太少或者太多的染色体存在。染色体数目多于或少于23个的胚胎可能会增加流产或某些遗传性疾病的风险。通过PGS筛选出异常胚胎和健康胚胎,医生可以只移植一个染色体正常的胚胎,增加怀孕的机会,以帮助患者有一个成功的单胎妊娠和健康的孩子。
但需要注意的是,母亲年龄在婴儿出生率中起着重要作用。35岁以下妇女的产后活产率也无法达到百分之百,35至40岁妇女的活产率下降到55%。对于41至43岁的妇女,活产率只会更低。
但由于每个人的身体条件不同,囊胚通过,PGS基因筛查的通过率也不完全相同。如果女性卵巢功能好,卵子质量好,精子活力强,没有异常,通过基因检测的概率还是很高的。所以还是建议想要做试管婴儿的朋友在,在做试管婴儿之前,好好的调理身体,尽量提高卵子和精子的质量。
相关资讯
更多>热门百科
更多>附近医院
更多>